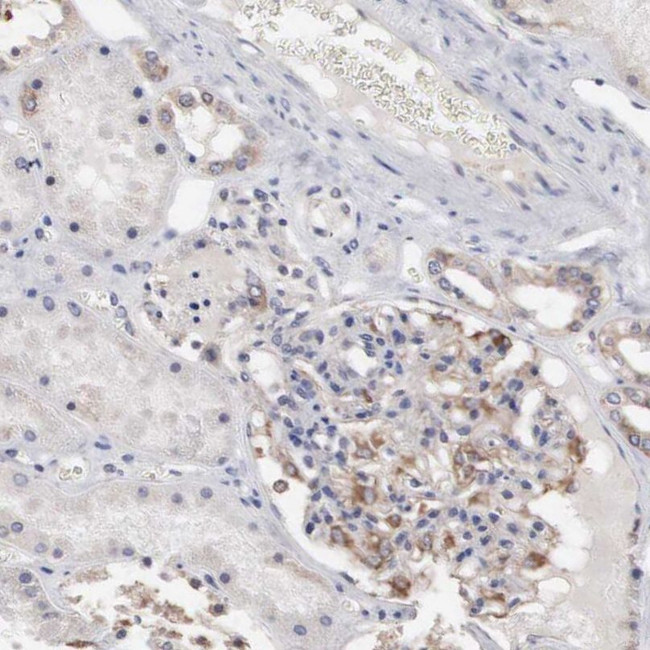
INF2 Antibody in Immunohistochemistry (IHC)

Search
Invitrogen
INF2 Polyclonal Antibody
{{$productOrderCtrl.translations['antibody.pdp.commerceCard.promotion.promotions']}}
{{$productOrderCtrl.translations['antibody.pdp.commerceCard.promotion.viewpromo']}}
{{$productOrderCtrl.translations['antibody.pdp.commerceCard.promotion.promocode']}}: {{promo.promoCode}} {{promo.promoTitle}} {{promo.promoDescription}}. {{$productOrderCtrl.translations['antibody.pdp.commerceCard.promotion.learnmore']}}
产品信息
PA5-51447
种属反应
宿主/亚型
分类
类型
抗原
偶联物
形式
浓度
纯化类型
保存液
内含物
保存条件
运输条件
RRID
产品详细信息
Immunogen sequence: GVARISDALL QLTCVSCVRA VMNSRQGIEY ILSNQGYVRQ LSQALDTSNV MVKKQVFELL AALCIYSPEG HVLTLDALDH YKTVCSQQYR FSIVMNELSG SDNVPYVVTL LSVINAVILG PEDLRARTQL RNEFIGLQLL DVLAR
Highest antigen sequence identity to the following orthologs: Mouse - 90%, Rat - 90%.
靶标信息
This gene represents a member of the formin family of proteins. It is considered a diaphanous formin due to the presence of a diaphanous inhibitory domain located at the N-terminus of the encoded protein. Studies of a similar mouse protein indicate that the protein encoded by this locus may function in polymerization and depolymerization of actin filaments. Mutations at this locus have been associated with focal segmental glomerulosclerosis 5.
仅用于科研。不用于诊断过程。未经明确授权不得转售。
篇参考文献 (0)
生物信息学
蛋白别名: HBEAG-binding protein 2 binding protein C; HBEBP2-binding protein C; inverted formin; inverted formin 2; inverted formin, FH2 and WH2 domain containing; Inverted formin-2; MGC13251; unnamed protein product
基因别名: C14orf151; C14orf173; CMTDIE; FSGS5; INF2; pp9484
UniProt ID: (Human) Q27J81
Entrez Gene ID: (Human) 64423